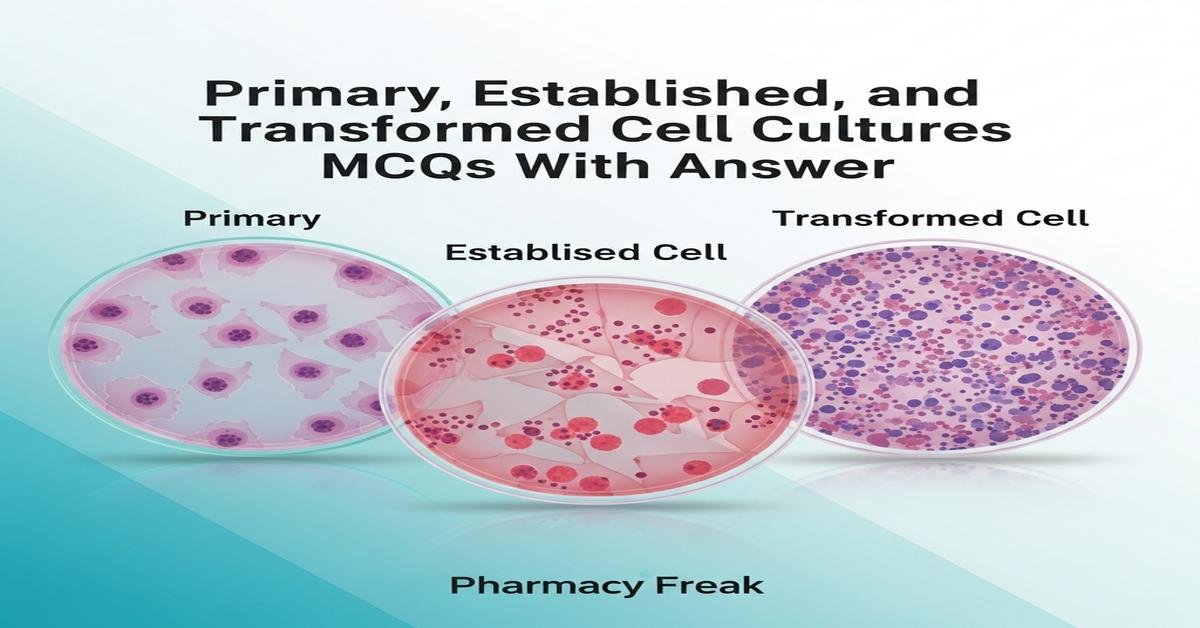
Primary, established and transformed cell cultures MCQs With Answer

Primary, established and transformed cell cultures MCQs With Answer is a focused revision resource for M.Pharm students preparing for exams in Cellular and Molecular Pharmacology. This set of questions covers the biology, techniques, and practical implications of working with primary cultures, established (continuous) cell lines, and transformed cells. Emphasis is placed on differences in lifespan, growth behavior, genetic stability, and applications in drug discovery, toxicity testing and mechanistic studies. The quiz reinforces concepts such as senescence, immortalization mechanisms, anchorage dependence, contamination issues and culture maintenance strategies, helping students consolidate both theoretical knowledge and laboratory interpretation skills.
Q1. Which characteristic best distinguishes a primary cell culture from an established cell line?
- Unlimited proliferative capacity through many passages
- Derived directly from fresh tissue and limited lifespan in vitro
- Always aneuploid and genetically unstable
- Requires viral oncogenes to grow in culture
Correct Answer: Derived directly from fresh tissue and limited lifespan in vitro
Q2. What defines a transformed cell in the context of cell culture?
- Cells that retain strict contact inhibition and normal morphology
- Cells that have acquired properties such as loss of contact inhibition and anchorage independence
- Primary cells maintained only for one passage
- Cells that require feeder layers for growth
Correct Answer: Cells that have acquired properties such as loss of contact inhibition and anchorage independence
Q3. Which process is most associated with immortalization of a cell line?
- Activation of telomerase or alternative lengthening of telomeres (ALT)
- Permanent cell cycle arrest via p53 induction
- Immediate apoptosis after plating
- Increased sensitivity to contact inhibition
Correct Answer: Activation of telomerase or alternative lengthening of telomeres (ALT)
Q4. Which of the following cell types is most commonly used as an example of an established continuous human cell line?
- Hepatocytes freshly isolated from biopsy
- HeLa cells
- Primary human dermal fibroblasts at passage 1
- Peripheral blood mononuclear cells (PBMCs)
Correct Answer: HeLa cells
Q5. Which statement about contact inhibition is true?
- Transformed cells typically show strong contact inhibition
- Contact inhibition prevents cells from entering apoptosis
- Normal primary cells stop proliferating when they reach confluence due to contact inhibition
- Contact inhibition is independent of cell–cell adhesion molecules
Correct Answer: Normal primary cells stop proliferating when they reach confluence due to contact inhibition
Q6. Which assay is most appropriate to assess anchorage-independent growth of transformed cells?
- Clonogenic assay on rigid glass
- Colony formation in soft agar
- Trypan blue exclusion viability
- MTT colorimetric assay on attached cells
Correct Answer: Colony formation in soft agar
Q7. What is a major risk when using long-established cell lines without authentication?
- Guaranteed maintenance of primary cell behavior
- Risk of cross-contamination and misidentification, leading to invalid conclusions
- Improved chromosomal stability over time
- Absolute absence of viral contaminants
Correct Answer: Risk of cross-contamination and misidentification, leading to invalid conclusions
Q8. In the context of cell culture, what does “passage number” indicate?
- The number of days since initial tissue harvest
- The cumulative number of times cells have been subcultured or split
- The number of chromosomes in the cell
- The temperature at which culture is maintained
Correct Answer: The cumulative number of times cells have been subcultured or split
Q9. Which of the following is a hallmark of senescence in primary cultured cells?
- Progressive shortening of telomeres leading to permanent growth arrest
- Unrestricted proliferation and tumor formation in vivo
- Immediate transformation into immortal cell lines
- Gain of anchorage independence
Correct Answer: Progressive shortening of telomeres leading to permanent growth arrest
Q10. Which viral agent was historically used to transform rodent fibroblasts and create immortal cell lines in the lab?
- Adeno-associated virus (AAV)
- Simian virus 40 (SV40)
- Influenza A virus
- Human immunodeficiency virus (HIV)
Correct Answer: Simian virus 40 (SV40)
Q11. Which culture condition is most critical for the initial establishment of a primary epithelial cell culture?
- Omitting extracellular matrix components to prevent attachment
- Providing appropriate substratum such as collagen or laminin and optimized growth factors
- Maintaining cells at 4°C for extended periods
- Using high concentrations of trypsin continuously
Correct Answer: Providing appropriate substratum such as collagen or laminin and optimized growth factors
Q12. For toxicology screening, why might researchers prefer established cell lines over primary cultures?
- Established lines are always more physiologically relevant than primary cells
- Established lines offer reproducibility, ease of culture and consistent responses across assays
- Primary cultures never express drug metabolizing enzymes
- Established lines eliminate the need for any controls
Correct Answer: Established lines offer reproducibility, ease of culture and consistent responses across assays
Q13. What is a common method for detecting mycoplasma contamination in cell cultures?
- Observation of increased cell adhesion under microscope
- PCR-based assays or fluorescent DNA staining specific for mycoplasma
- Counting cell number with a hemocytometer only
- Measuring oxygen consumption and assuming contamination if low
Correct Answer: PCR-based assays or fluorescent DNA staining specific for mycoplasma
Q14. Which genetic feature is most likely to change in transformed cell lines compared with the original primary cells?
- Maintenance of diploid karyotype without variation
- Chromosomal instability and aneuploidy
- Complete restoration of telomere length regulation by p53
- Absolute preservation of tissue-specific gene expression
Correct Answer: Chromosomal instability and aneuploidy
Q15. When deriving a clonal cell line from a heterogeneous culture, which technique is commonly used?
- Limiting dilution cloning or single-cell sorting by flow cytometry
- Incubating bulk culture without splitting for months
- Mixing cultures from different species
- Continuous exposure to high-dose antibiotics
Correct Answer: Limiting dilution cloning or single-cell sorting by flow cytometry
Q16. Why is serum often reduced or withdrawn in assays measuring drug effects on cultured cells?
- Serum has no effect on drug bioavailability in vitro
- Serum contains growth factors and binding proteins that can sequester drugs and confound results
- Reducing serum increases contamination risk deliberately
- Serum withdrawal instantly immortalizes primary cells
Correct Answer: Serum contains growth factors and binding proteins that can sequester drugs and confound results
Q17. Which approach helps maintain genetic fidelity and reduce drift in established cell line stocks?
- Continuous culture for hundreds of passages without backup
- Creating low-passage frozen master stocks and using aliquots for experiments
- Never checking cell identity or contamination
- Frequently mixing cell lines to increase heterogeneity
Correct Answer: Creating low-passage frozen master stocks and using aliquots for experiments
Q18. What role do feeder layers play in the culture of certain primary or stem cells?
- They provide a physical nuclear scaffold for DNA replication
- They supply extracellular signals, growth factors and support for attachment and proliferation
- They cause immediate cell transformation
- They are used to increase the rate of senescence
Correct Answer: They supply extracellular signals, growth factors and support for attachment and proliferation
Q19. Which statement best describes the doubling time of a cell line?
- The time required for the entire culture to die
- The time for a cell population to double in number during exponential growth phase
- The time a cell spends in mitosis only
- The fixed lifespan of a primary cell in vitro in days
Correct Answer: The time for a cell population to double in number during exponential growth phase
Q20. In studies of carcinogenesis, why are transformed cell cultures valuable models?
- They perfectly recapitulate the in vivo tumor microenvironment in all aspects
- They allow dissection of molecular pathways of transformation and screening of anti-cancer agents under controlled conditions
- They are always non-tumorigenic in animal models
- They cannot be genetically manipulated
Correct Answer: They allow dissection of molecular pathways of transformation and screening of anti-cancer agents under controlled conditions